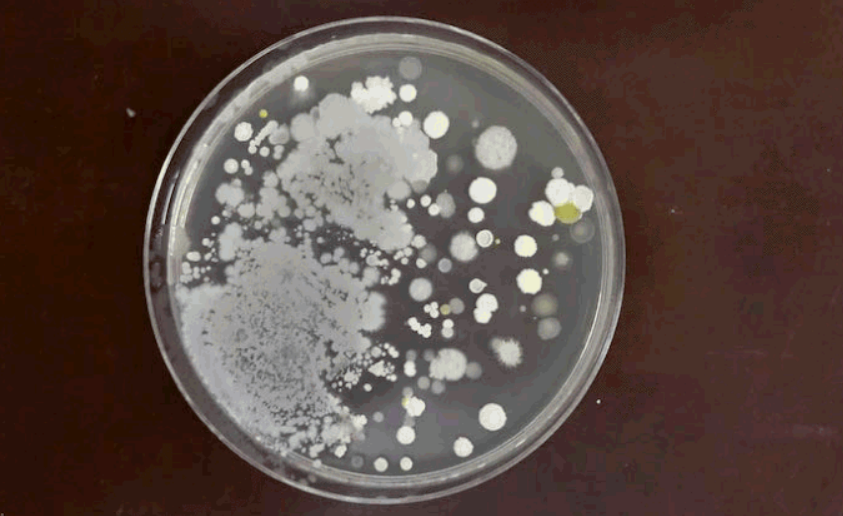

原创 女儿总说屁屁痒,宝妈凑近一看,吓得汗毛都立起来了
提示您本文原始标题是:女儿总说屁屁痒 , 宝妈凑近一看 , 吓得汗毛都立起来了
文/孕婴帮 , 欢迎个人转发分享!
每年的七八月份 , 都是孩子的假期时间 。 相信有不少家庭的孩子 , 已经放假在家了 。 很多家长因为工作没有假期 , 就让孩子回老家和爷爷奶奶过暑假 。 小玲女儿的幼儿园也放暑假了 , 吵着要回老家玩 。 正好小玲这段时间工作忙 , 就让女儿自己回去了 。
孩子从老家回来后 , 就总说自己屁屁痒 , 不停地挠 。 小玲发现她的屁屁上有一些小红点 , 以为是小儿皮肤病 , 没有太过在意 , 用了一些硫磺皂给孩子洗澡 , 以为这样就可以了 。 可是并没有任何改善 , 孩子过了几天说更痒了 。 这时候小玲意识到不对劲 , 凑近一看孩子的屁屁 , 发现上面的小红点已经流血化脓了 , 这给小玲吓得汗毛都起来了了 , 赶紧送到医院 。

---- 原创 女儿总说屁屁痒 , 宝妈凑近一看 , 吓得汗毛都立起来了 //---- http:// //
医生诊断后说这不是皮肤病 , 而是寄生虫感染 , 是不注意卫生导致的 。 女儿说自己在老家的时候 , 爷爷奶奶怕她夏天太热了 , 就让她不要穿小裤裤 , 这样会凉快一些 。 小玲听完后冷汗直流 , 孩子的卫生太重要了 。 还好这个寄生虫感染不是特别严重 , 用药物治疗就能好 。
儿童卫生是每个家长都应该重视的问题 , 做好幼儿个人卫生教育 , 让孩子养成卫生的习惯可以有效避免各种疾病 。

---- 原创 女儿总说屁屁痒 , 宝妈凑近一看 , 吓得汗毛都立起来了 //---- http:// //
第一 , 个人卫生 。 个人卫生要让孩子养成自立的习惯 。
1、勤洗澡、勤换衣物 , 在户外不要裸露身体 , 保持衣服干爽可以避免因为潮湿而出现细菌感染 。
2、勤剪指甲 。 有的孩子追求潮流 , 喜欢把指甲留长 , 但是指甲留长很容易滋生细菌 , 加上平时吃东西都会用到手 , 就容易导致病从口入 。
3、饭前便后要洗手 。 吃饭之前和上完厕所后都应该好好把手洗干净 , 不然手上就容易携带病菌 , 导致手足口病 。
---- 原创 女儿总说屁屁痒 , 宝妈凑近一看 , 吓得汗毛都立起来了 //---- http:// //
第二 , 饮食卫生 。 正所谓病从口入 。 现在很多学校周边都有卖街边小吃 , 受到很多孩子的欢迎 。 但是这样的街边小吃 , 长期处于没有卫生安全保障的露天状态 , 马路上的灰尘和细菌都会飞到食物上 , 孩子经常吃这些街边小吃很容易引起肠胃疾病 。 为孩子挑选食物的时候 , 要注意去一些到达卫生安全标准的店 , 这样孩子的饮食卫生才有保障 。
第三 , 室内卫生 。 孩子的房间要让孩子学会整理和打扫 , 不要在地上乱扔垃圾 , 家长要规律使用消毒水拖地 , 保持一个干净整洁的室内环境 , 孩子感染上细菌的机会才能减少 。 如果家里的环境脏乱 , 孩子感染上细菌的可能性就会大大增加 。

---- 原创 女儿总说屁屁痒 , 宝妈凑近一看 , 吓得汗毛都立起来了 //---- http:// //
第四 , 室外卫生 。 很多家长喜欢带孩子到室外去玩耍 , 这时候要注意让孩子穿好贴身衣物 。 必要的时候可以带上长衣长裤 , 避免蚊虫叮咬 。 在去游乐场等地方的时候 , 孩子玩完了要注意让孩子洗干净手 , 如果出汗了就及时更换衣物 。
孩子的免疫力本就没有大人的强 , 因此更需要我们去呵护 。 只有细心的呵护 , 才能让孩子更健康地成长起来 。
我是帮妈 , 一名高级育婴师 , 私信“育儿” , 帮您解答带娃路上的困扰~
(配图均来自网络 , 侵权删 。 )
- 「母婴和育儿」原创宝宝鼻腔深处有鼻屎,尝试各种方法后,最后这样做成功了
- 「母婴和育儿」原创宝宝和大人睡?给宝宝睡婴儿床?到底哪个选择才是对的?
- 晓露爸爸@原创“红脸宝宝”火了,两个脸蛋红的像苹果,网友:不会是喝奶喝醉了吧
- #育儿房间#原创儿童已成白血病高发群体:这些水果“隐患”,最好少给孩子吃
- [育儿房间]原创“妈妈,我蛋蛋疼”,本以为孩子只是磕到了,谁知差点出了大事
- 宝妈育儿微课■原创4岁孩子贪玩吞水银,奶奶非拦着先“吃菜”才送医,医生:做得对
- 趣儿养母:原创新手妈妈面对宝宝哭常常束手无措,首先如何分辨宝宝的哭声很重要
- 「jason妈咪有办法」原创孩子打喷嚏流鼻涕发烧时,不妨试试这些绿色疗法,管用
- #书里缘#原创父母的洁癖会破坏孩子的免疫力,你信吗?
- 『儿科医生雨滴』原创给宝宝穿这种裤子可能有这四个危害,你一定要知道
